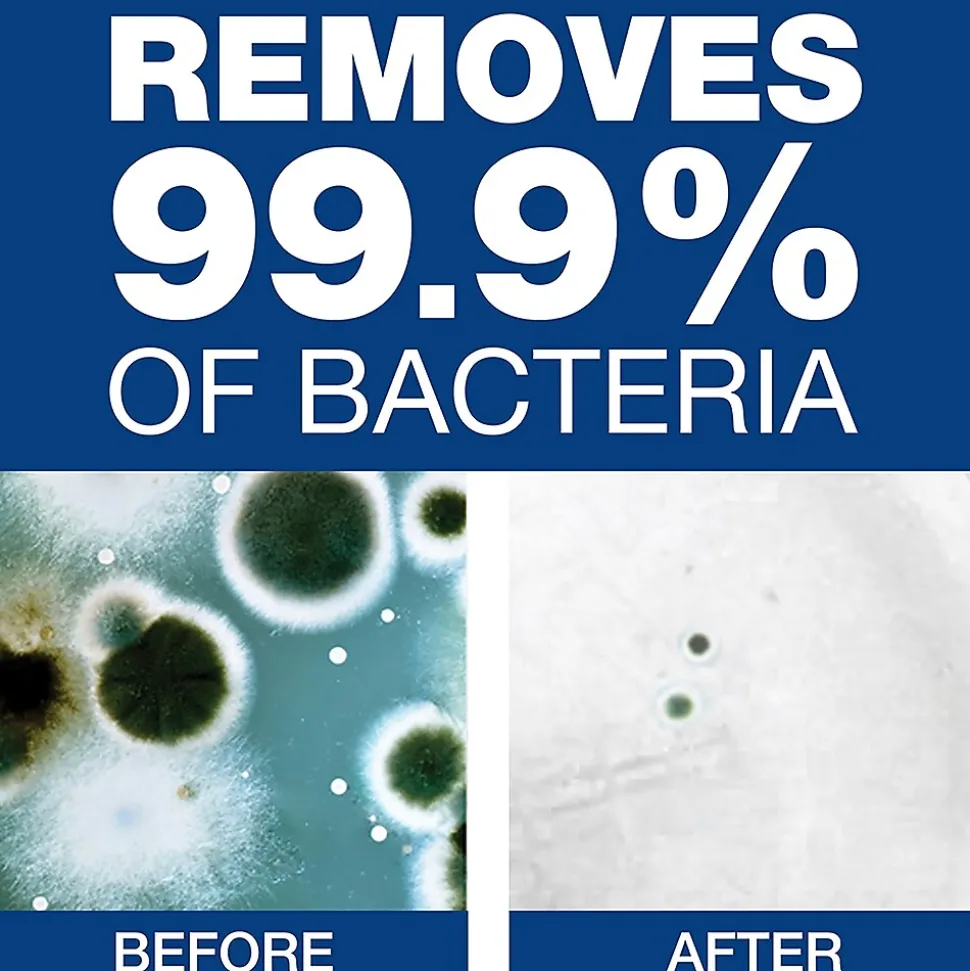

Safeguard Professional Antibacterial Liquid Hand Soap, 1 gal., 2/Carton (2699)
$62.00 Original price was: $62.00.$44.89Current price is: $44.89.
Washing your hands is one of the most important steps you can take to reduce the spread of germs and prevent illnesses. Safeguard liquid hand soap is designed for safe, simple and effective hand hygiene.
- Antibacterial hand soap delivers more than 1,700 hand washes per cartridge
- Powerful surfactant-based formula washes away dirt and bacteria
- Kills 99% of dangerous bacteria* (*Listeria monocytogenes (ATCC 19114))
- Hand soap with a pleasant scent
- Automated dispensers and dispenser stands are available
| Attribute name | Attribute value |
|---|---|
| Antibacterial | Non FDA Compliant |
| Concentrated or Ready To Use | 1 |
| Capacity (ml.) Weight of the product measured in pounds. | 17.87 |
| Kill Claim (%) | 2 |
| Refill | Antimicrobial |
| Capacity (oz.) The scent of the product. (For Example: Cherry, Fresh Peach, Unscented) | Light |
| Width in Inches | Other |
| Dispenser Required | Yes |
| True Color | Screw Top Bottle |
| Height in Inches | Liquid Soap |
Be the first to review “Safeguard Professional Antibacterial Liquid Hand Soap, 1 gal., 2/Carton (2699)” Cancel reply
Related products
Cleaning Supplies
Cleaning Gloves
Ansell Evolution One® Natural Clear Powder-Free Latex Exam Gloves, Size Large, 100/BX (EV-2050)
All-Purpose Cleaners
All-Purpose Cleaners
Scrubbing Bubbles Bathroom Grime Fighter Cleaner, Citrus, 32 Oz. (306111)
All-Purpose Cleaners
All-Purpose Cleaners
PURELL Professional Surface Disinfectant Spray, Fresh Citrus Scent, 32 oz. (3342-06)
All-Purpose Cleaners
Coastwide Professional Degreaser Triple Power, 3.78L, 4/Carton (CW391001-A)
All-Purpose Cleaners
PURELL Professional Surface Disinfectant Spray, Fresh Citrus Scent, 32 oz., 6/Carton (3342-06CT)
All-Purpose Cleaners
CloroxPro Toilet Bowl Cleaner with Bleach, Fresh Scent, 24 fl. oz. (00031)
Cleaning Supplies

Reviews
There are no reviews yet.